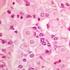
CITOLOGÍA E HISTOLOGÍA VETERINARIA

Cintya Borroni G. MV. Msc
|
|
|
- Amparo Valverde Calderón
- hace 9 años
- Vistas:
Transcripción
1 EMBRIOLOGÍA DEL SIST. NERVIOSO Cintya Borroni G. MV. Msc
2 EMBRIOLOGÍA DEL SIST. NERVIOSO
3 EMBRIÓN TRILAMINAR Hoja superior del embrión queda formada por el neuroectodermo.
4 Neurulación Células de neuroectoderma se hacen altas y cilíndricas, originando la placa neural. Bordes laterales de la placa se solevantan, formando el surco neural. Luego se fusionan constituyendo el tubo neural (comienza en región cervical).
5 Neurulación Durante el cierre del surco neural se desprenden células lateralmente, se denominan crestas neurales. Tubo neural de región cefálica se dilatan, formando las vesículas encefálicas: Prosencéfalo, mesencéfalo y rombencéfalo. Engrosamiento de ectoderma corresponden a placodas olfatorias, ópticas, óticas y epibranquiales. Crestas neurales: Origen SNP Tubo neural: Origen SNC Placodas: Origen órg. De los sentidos
6 Neurulación El tubo neural presenta 3 capas: - Germinal (ventricular o ependimaria): Hacia la luz del conducto y corresponde a la zona proliferativa. - Manto (intermedia): Neuroblastos y glioblastos. Sustancia gris. - Marginal: Prolongaciones neuronales. Sustancia blanca.
7 Neurulación
8 Desarrollo del SNC (Encéfalo) Prosencéfalo: Telencéfalo y diencéfalo. Mesencéfalo Rombencéfalo: Metencéfalo (origen de cerebelo) y mielencéfalo.
9 Desarrollo del SNC
10 Desarrollo del SNC Como consecuencia del desarrollo de las vesículas el neurocele (cav. Del tubo neural) sufre modificaciones. En la médula espinal se estrecha: cond. Central de la médula. En el rombencéfalo y prosencéfalo se dilata: IV, III, II y I (laterales) Ventrículo respectivamente. En el mesencéfalo se estrecha: Acueducto mesencefálico.
11
12 Desarrollo del SNC (Médula espinal) Capa del manto formará la sust. Gris. Capa marginal formará la sust. Blanca. Cuernos laterales sólo en segmento torácico.
13 Desarrollo del SNP Células de las crestas neurales migran mayoritariamente hacia ventral, originando ganglios de la cadena simpática, médula adrenal, ganglios abdominales, entre otros. Células de las crestas neurales a nivel cefálico formarán tej. Conjuntivo y musc. esquelético de la cabeza.
14
15 HISTOLOGÍA DEL SIST. NERVIOSO Cintya Borroni G. MV. Msc
16 TEJIDO NERVIOSO Constituido por: Tejido conjuntivo - SNC forma las meninges y acompaña vasos sanguíneos - SNP se asocia a ganglios, nervios y órganos sensoriales Neuronas - Especializadas en recibir y transmitir impulsos nerviosos - Capaces de procesar información Neuroglias, glías (cél. de sostén) - 90% de las células que forman el sist. Nervioso - Células no conductoras, estrechamente asociadas a neuronas - Otorgan soporte, defensa y nutrición a las neuronas
17 NEURONA Clasificación funcional: Neuronas sensitivas - Impulsos desde receptores hacia SNC. - Fibras aferentes somáticas: dolor, t, tacto, p, propiocepción. - Fibras aferentes viscerales: dolor y otras sensaciones de mucosa, glándulas y vasos sanguíneos. Neuronas motoras - Impulsos desde SNC. - Eferentes somáticas: músc. Esqueléticos. - Eferentes viscerales: músc. Liso, cardiaco y glándulas. Interneuronas (neuronas intercalares) - Red entre neuronas sensitivas y motoras. - Más del 99,9% de las neuronas corresponde a este tipo.
18 NEURONA Zona dendrítica Zona de conducción Zona telodendrítica
19 NEURONA Clasificación según cantidad de prolongaciones Unipolar: Un axón que se divide cerca del soma. Sensitivas. Nervios craneales y ganglio Bipolar: Un axón y una dendrita. Sensoriales. Retina, nervio VIII. Multipolar: Un axón y dos o más dendritas. Motoras e interneuronas. Son las más abundantes.
20 Soma neuronal (cuerpo o pericarion) Núcleo Citoplasma: En microscopía óptica el contenido ribosómico aparece como granulaciones denominadas corpúsculos de Nissl. N: Núcleo. Nu: Nucléolo. G: Aparato de Golgi. D: Dendritas. A: Axón. AH: Cono axónico. Cap: Capilar. NB: R.E.R. (Nissl body). BT: Terminal axónico. Lf: Gránulos de lipofuscina. Nf: Neurofibrillas (NT y NF). Ly: Lisosomas.
21 Soma neuronal Las neuronas no se dividen, sin embargo hay sectores del encéfalo que presentan células madre nerviosas que son capaces de diferenciarse y reemplazar a neuronas lesionadas.
22
23 Dendritas Diámetro mayor que los axones, hacia extremo se adelgazan y no presentan mielinización. Sus extensas ramificaciones se denominan arborización dendrítica. Presentan los mismos organelos que el soma. Espina dentrítica: Proyecciones receptivas de las dendritas, donde se generan las sinápsis. Neurona de purkinje
24 Axón Transmite información hacia otra neurona o hacia una célula efectora. Es de longitud variable y diámetro constante. Axolpasma contiene: neurofilamentos, mitocondrias y vesículas de transporte. Axón termina en una arborización denominada telodendrón que terminan en botones sinápticos.
25 Sinapsis Regiones de contacto especializadas entre las neuronas o entre éstas y células efectoras. Comprende un elemento presináptico, hendidura (espacio) sináptica y elemento postsináptico. Las sinapsis entre neuronas se clasifican en: - Axodendrítica: Entre axones y dendritas. - Axosomáticas: Entre axones y soma neuronal. - Axoaxónica: Entre axones.
26 Sinapsis
27 Sinapsis Clasificación fisiológica: - Exitatoria - Inhibitoria Clasificación bioquímica: - Química: Liberación de neurotransmisores como aminoácidos, péptidos, monoaminas, entre otras. - Eléctrica: Movimiento de iones entre células. Músculo liso y cardiaco. En invertebrados.
28 Botón presináptico Hendidura sináptica Membrana postsináptica Sinapsis química
29 NEUROGLIAS SNC En los preparados histológicos de rutina sólo se aprecian los núcleos de las glías. Para más detalle se realizan técnicas de impregnación de metales o inmunohistoquímica. Ependimocitos Astrocitos Ologidendrocitos Microglia
30 Ependimocitos Forman un epitelio cúbico y presentan microbellosidades. Revisten ventrículos encefálicos y conducto central de la médula. Plexos coroideos: Ependimocitos modificados.
31 Astrocitos Mayor tamaño de las glías. Atrocitos protoplasmáticos: En sust. Gris. Abundantes prolongaciones citoplasmáticas cortas y ramificadas. Astrocitos fibrosos: En sust. Blanca, prolongaciones menos abundantes y más rectas. Las prolongaciones terminan en expansiones denominadas pies vasculares. Presentan filamentos intermedios compuestos de una proteína ácida glialfibrilar (GFAP) que es única de los astrocitos (marcador de esclerosis múltiple).
32 Astrocitos Funciones: Eliminan iones y remanentes del metabolismo neuronal (neurotransmisores). Regula la llegada de metabolitos adecuados para la neurona Constituye la barrera hematoencefálica Se incorporan a áreas dañadas del s. nervioso para generar tej. Cicatricial.
33 Oligodendrocitos Células pequeñas encargadas de la formación y mantenimiento de la vaina de mielina. La vaina de mielina se forma por capas concéntricas de la membrana plasmática del oligodendrocito.
34 Oligodendrocitos
35 Microglia Se forman a partir del mesodermo. Son las de menor tamaño de las glías, tienen un núcleo pequeño y alargado. Presentan espinas en su cuerpo y prolongaciones. Corresponden a los macrófagos del s. nervioso, funcionan como fagocitos, eliminando desechos y estructuras dañadas del s. nervioso. Involucradas en la inflamación y reparación del SNC.
36
37
38 NEUROGLIAS SNP Células de Schwann o neurolemmocitos Células satélite o anficitos Células de Schwann Células aplanadas Envuelven axones mielínicos y amielínicos Producen la vaina de mielina Entre células existe un espacio Nodo de Ranvier
39 Célula de Schwann Fibras amielínicas Fibras mielínicas
40 Células satélites Células cúbicas pequeñas que rodean a los somas neuronales en los ganglios. Establecen y mantienen un microambiente al soma. Función de relleno, nutrición y protección
41 SNC Sustancia blanca: - Axones mielinizados - Astrocitos fibrosos - Oligodendrocitos Sustancia gris: - Somas neuronales -Fibras amielínicas, mielínicas escasas - Astrocitos protoplasmáticos -Oligodendrocitos - Neuropilo (Conj. De axónes, telodendrón, dendritas y prolongaciones gliales). Neuropilo
42 Folias separadas por surcos. Sustancia blanca central y gris periférica. CEREBELO Corteza cerebelosa: - Capa molecular: Neuropilo - Células de purkinje: Células piriformes cuyas prolongaciones se extienden hacia la sustancia blanca. - Capa granular: Junto a la sust. Blanca. Característica presencia de abundantes células granulares.
43
44 CEREBRO Giros y surcos. Sustancia blanca central y gris periférica. 6 capas de corteza Corteza cerebral: - Capa molecular: Neuropilo. - Capa granular externa: Neuronas pequeñas. - Capa piramidal externa: Neuronas piramidales medianas y pequeñas. - Capa granular interna: Capa receptora de aferencias sensoriales, formada por neuronas estrelladas. - Capa piramidal interna: Neuronas piramidales medianas y grandes, gruesa capa en área motora. - Capa fusiforme: Neuronas fusiformes.
45
46 MENINGES Duramadre: - Fibras colágenas orientadas diversamente. -Tejido conectivo denso Aracnoides: -Tejido conectivo más laxo - Trabéculas aracnoídeas hacia piamadre Piamadre: - Tejido conectivo laxo reticular
47 Plexos coroídeos Se originan en regiones de los ventrículos donde la pared está formada por células ependimarias y piamadre. Epitelio cuboídeo simple. Producen el LCE por ultrafiltrado sanguíneo.
48 SIST. NERVIOSO PERIFÉRICO
49 SIST. NERVIOSO PERIFÉRICO Ganglios - Somas - Fibras mielínicas y amielínicas - Células satélites y de Schwann Nervios - Fibras mielínicas y amielínicas - Células de Schwann
50 Tej. Conectivo de un nervio Endoneuro: Tej. Conectivo laxo que rodea a una fibra nerviosa. Perineuro: Tej. Conectivo especializado que rodea a fascículos nerviosos (conj. De fibras). Epineuro: Tej. Conjuntivo denso que rodea a un nervio
51
52 Ganglio
53 Ganglio
SESIÓN 10 UNIDAD: TEJIDO NERVIOSO..
 SESIÓN 10 UNIDAD: TEJIDO NERVIOSO.. I.- OBJETIVOS DE LA SESIÓN: Al término de la sesión, los alumnos deberán ser capaces de: Definir el concepto de tejido nervioso, como un tejido altamente especializado,
SESIÓN 10 UNIDAD: TEJIDO NERVIOSO.. I.- OBJETIVOS DE LA SESIÓN: Al término de la sesión, los alumnos deberán ser capaces de: Definir el concepto de tejido nervioso, como un tejido altamente especializado,
Tejido Nervioso. Kinesiologia. Professor: Verónica Pantoja. Lic. MSP.
 Tejido Nervioso Professor: Verónica Pantoja. Lic. MSP. Kinesiologia Objetivo: Identificar las principales estructuras y características histológicas del tejido nervioso IPCHILE DOCENTE:Veronica Pantoja
Tejido Nervioso Professor: Verónica Pantoja. Lic. MSP. Kinesiologia Objetivo: Identificar las principales estructuras y características histológicas del tejido nervioso IPCHILE DOCENTE:Veronica Pantoja
SISTEMA NERVIOSO: MORFOFISIOLOGÍA
 SISTEMA NERVIOSO: MORFOFISIOLOGÍA SISTEMA NERVIOSO El sistema nervioso permite que el organismo responda a los cambios del medio externo e interno. Este controla e integra las actividades funcionales de
SISTEMA NERVIOSO: MORFOFISIOLOGÍA SISTEMA NERVIOSO El sistema nervioso permite que el organismo responda a los cambios del medio externo e interno. Este controla e integra las actividades funcionales de
TEJIDO NERVIOSO. Dr. Vittorio Zaffiri M. Marzo 2007
 TEJIDO NERVIOSO Dr. Vittorio Zaffiri M. Marzo 2007 Características y funciones básicas del tejido nervioso -Se origina en el ectoderma. -Principales componentes: -Células -Escaso material intercelular.
TEJIDO NERVIOSO Dr. Vittorio Zaffiri M. Marzo 2007 Características y funciones básicas del tejido nervioso -Se origina en el ectoderma. -Principales componentes: -Células -Escaso material intercelular.
Tejido Nervioso Las neuronas Las células gliales
 Tejido Nervioso Está formado por células y escasa sustancia extracelular. El material interpuesto entre las células no es un material predominante extracelular fibroso o amorfo como en el tejido conectivo,
Tejido Nervioso Está formado por células y escasa sustancia extracelular. El material interpuesto entre las células no es un material predominante extracelular fibroso o amorfo como en el tejido conectivo,
Generalidades de Sistema Nervioso
 Generalidades de Sistema Nervioso Ximena Rojas Universidad de Chile Sistema Nervioso El sistema nervioso incluye todo el tejido nervioso del cuerpo. Sus funciones son: Proveer información acerca de los
Generalidades de Sistema Nervioso Ximena Rojas Universidad de Chile Sistema Nervioso El sistema nervioso incluye todo el tejido nervioso del cuerpo. Sus funciones son: Proveer información acerca de los
Características típicas del tejido nervioso NEURONAS y CÉLULAS DE LA NEUROGLIA multiplicidad de neurotransmisores.
 Tejido Nervioso Características típicas del tejido nervioso: captación, conducción, elaboración, almacenamiento y transmisión de señales eléctricas. Está estructurado de una forma extraordinariamente compleja,
Tejido Nervioso Características típicas del tejido nervioso: captación, conducción, elaboración, almacenamiento y transmisión de señales eléctricas. Está estructurado de una forma extraordinariamente compleja,
Universidad Nacional del Nordeste Facultad de Medicina Cátedra II de Histología y Embriología
 Universidad Nacional del Nordeste Facultad de Medicina Cátedra II de Histología y Embriología Actividad N 6 Sistema nervioso. Órganos de los sentidos. SISTEMA NERVIOSO El Sistema Nervioso está compuesto
Universidad Nacional del Nordeste Facultad de Medicina Cátedra II de Histología y Embriología Actividad N 6 Sistema nervioso. Órganos de los sentidos. SISTEMA NERVIOSO El Sistema Nervioso está compuesto
Generalidades de Sistema Nervioso
 Generalidades de Sistema Nervioso Ximena Rojas Facultad de Medicina Universidad de Chile Sistema Nervioso El sistema nervioso incluye todo el tejido nervioso del cuerpo. Algunas funciones: Provee información
Generalidades de Sistema Nervioso Ximena Rojas Facultad de Medicina Universidad de Chile Sistema Nervioso El sistema nervioso incluye todo el tejido nervioso del cuerpo. Algunas funciones: Provee información
SISTEMA NERVIOSO CENTRAL (SNC)
 TEJIDO NERVIOSO Proporciona el medio por el cual es posible la comunicación instantánea entre las células de los distintos tejidos del organismo y entre ellas y el exterior. Se envían mensajes a través
TEJIDO NERVIOSO Proporciona el medio por el cual es posible la comunicación instantánea entre las células de los distintos tejidos del organismo y entre ellas y el exterior. Se envían mensajes a través
CELULAS DEL SISTEMA NERVIOSO CENTRAL. Universidad Intercontinental UIC
 CELULAS DEL SISTEMA NERVIOSO CENTRAL Universidad Intercontinental UIC Área de la Salud Facultad de Psicología Mtro. Gabriel Perea UNIDAD ELEMENTAL DEL SISTEMA NERVIOSO 2 Neuronas y neuroglia EL TEJIDO
CELULAS DEL SISTEMA NERVIOSO CENTRAL Universidad Intercontinental UIC Área de la Salud Facultad de Psicología Mtro. Gabriel Perea UNIDAD ELEMENTAL DEL SISTEMA NERVIOSO 2 Neuronas y neuroglia EL TEJIDO
EL SISTEMA NERVIOSO CENTRAL Y PERIFERICO. Prof. Glamil Acevedo Pietri Anatomía y Fisiología
 EL SISTEMA NERVIOSO CENTRAL Y PERIFERICO Prof. Glamil Acevedo Pietri Anatomía y Fisiología INTRODUCCIÓN Prioridad en el desarrollo: Primer sistema que se diferencia en la embriogénesis Que crece con mayor
EL SISTEMA NERVIOSO CENTRAL Y PERIFERICO Prof. Glamil Acevedo Pietri Anatomía y Fisiología INTRODUCCIÓN Prioridad en el desarrollo: Primer sistema que se diferencia en la embriogénesis Que crece con mayor
Sonia González Pineda
 UNIVERSIDAD DEL CAUCA FACULTAD CIENCIAS DE LA SALUD DEPARTAMENTO DE MORFOLOGÍA AREA DE HISTOEMBRIOLOGÍA Docente: MSc. SONIA GONZÁLEZ PINEDA. TEJIDO NERVIOSO En el cuerpo humano, tanto el sistema nervioso
UNIVERSIDAD DEL CAUCA FACULTAD CIENCIAS DE LA SALUD DEPARTAMENTO DE MORFOLOGÍA AREA DE HISTOEMBRIOLOGÍA Docente: MSc. SONIA GONZÁLEZ PINEDA. TEJIDO NERVIOSO En el cuerpo humano, tanto el sistema nervioso
LA NEURONA Historia. Concepto
 LA NEURONA Historia A fines del siglo XIX, Santiago Ramón y Cajal situó por vez primera las neuronas como elementos funcionales del sistema nervioso.4 Cajal propuso que actuaban como entidades discretas
LA NEURONA Historia A fines del siglo XIX, Santiago Ramón y Cajal situó por vez primera las neuronas como elementos funcionales del sistema nervioso.4 Cajal propuso que actuaban como entidades discretas
30/04/2010. SN1: Estructura del sistema nervioso. Anatomía y propiedades de las neuronas.
 SN1: Estructura del sistema nervioso. Anatomía y propiedades de las neuronas. SN2 Potencial de membrana o de reposo. Potencial de acción. Canales iónicos. SN3 Potencial de membrana o de reposo. Potencial
SN1: Estructura del sistema nervioso. Anatomía y propiedades de las neuronas. SN2 Potencial de membrana o de reposo. Potencial de acción. Canales iónicos. SN3 Potencial de membrana o de reposo. Potencial
Repaso de la Histología animal TEJIDO MUSCULAR
 Repaso de la Histología animal TEJIDO MUSCULAR Tejido muscular Células musculares: Especializadas en la conversión de energía química (ATP) en mecánica (movimiento y/o tensión) CONTRÁCTILES RELAJACIÓN
Repaso de la Histología animal TEJIDO MUSCULAR Tejido muscular Células musculares: Especializadas en la conversión de energía química (ATP) en mecánica (movimiento y/o tensión) CONTRÁCTILES RELAJACIÓN
Unidad 2. Neurona y Transmisión Sináptica. Estudio Anatomo-Funcional del Sistema Nervioso
 Unidad 2. Neurona y Transmisión Sináptica Estudio Anatomo-Funcional del Sistema Nervioso Objetivos Conocer los principales tipos de células nerviosas. Conocer la estructura externa e interna de la neurona.
Unidad 2. Neurona y Transmisión Sináptica Estudio Anatomo-Funcional del Sistema Nervioso Objetivos Conocer los principales tipos de células nerviosas. Conocer la estructura externa e interna de la neurona.
Biología. Ejercicios PSU. Programa Electivo Ciencias Básicas. GUÍA PRÁCTICA Organización del sistema nervioso I GUICEL003BL11-A16V1
 Ejercicios PSU 1. Una persona presenta un tumor en el cerebro, que corresponde a una proliferación anormal de células. Es probable que este tumor se haya originado a partir de A) B) C) 2. III) A) B) C)
Ejercicios PSU 1. Una persona presenta un tumor en el cerebro, que corresponde a una proliferación anormal de células. Es probable que este tumor se haya originado a partir de A) B) C) 2. III) A) B) C)
Trabajo Final: Curso de Neurobiología y Plasticidad Neuronal
 Trabajo Final: Curso de Neurobiología y Plasticidad Neuronal Alumno: Horacio Hernández www.asociacioneducar.com Mail: [email protected] Facebook: www.facebook.com/neurocienciasasociacioneducar
Trabajo Final: Curso de Neurobiología y Plasticidad Neuronal Alumno: Horacio Hernández www.asociacioneducar.com Mail: [email protected] Facebook: www.facebook.com/neurocienciasasociacioneducar
Está formada por el cuerpo celular y diferentes prolongaciones:
 TEMA II Sistema nervioso El sistema nervioso es una red de tejidos altamente especializada, que tiene como componente principal a las neuronas, células que se encuentran conectadas entre sí de manera compleja
TEMA II Sistema nervioso El sistema nervioso es una red de tejidos altamente especializada, que tiene como componente principal a las neuronas, células que se encuentran conectadas entre sí de manera compleja
2.5 - Tejido nervioso
 2.5 - Tejido nervioso Tejido especializado en la transmisión de información Se basa en una células llamadas Células nerviosas o Neuronas Estas células necesitan la ayuda de células auxiliares: células
2.5 - Tejido nervioso Tejido especializado en la transmisión de información Se basa en una células llamadas Células nerviosas o Neuronas Estas células necesitan la ayuda de células auxiliares: células
TEMA 6: ORGANIZACIÓN GENERAL DEL SISTEMA NERVIOSO
 TEMA 6: ORGANIZACIÓN GENERAL DEL SISTEMA NERVIOSO Sistema nervioso central (SNC): Centro estructural y funcional: encéfalo + médula espinal Sistema nervioso periférico (SNP): Vías nerviosas externas al
TEMA 6: ORGANIZACIÓN GENERAL DEL SISTEMA NERVIOSO Sistema nervioso central (SNC): Centro estructural y funcional: encéfalo + médula espinal Sistema nervioso periférico (SNP): Vías nerviosas externas al
Guía de Estudio: Sistema Nervioso Neurona. Nombre alumno ( a ) III
 Departamento de Ciencias y Tecnología Prof. Christian Contreras G. Guía de Estudio: Sistema Nervioso Neurona Nombre alumno ( a ) III Tomado: www.educarchile.cl Para sobrevivir, los animales requieren mantener
Departamento de Ciencias y Tecnología Prof. Christian Contreras G. Guía de Estudio: Sistema Nervioso Neurona Nombre alumno ( a ) III Tomado: www.educarchile.cl Para sobrevivir, los animales requieren mantener
El sistema nervioso central: El encéfalo y la médula espinal
 El sistema nervioso central: El encéfalo y la médula espinal El sistema nervioso central: El encéfalo y la médula espinal El sistema nervioso central lo forman: El encéfalo La médula espinal El sistema
El sistema nervioso central: El encéfalo y la médula espinal El sistema nervioso central: El encéfalo y la médula espinal El sistema nervioso central lo forman: El encéfalo La médula espinal El sistema
EL SISTEMA NERVIOSO 1. La comunicación nerviosa neuronas células de neuroglia. receptores circuitos neuronales efectores
 EL SISTEMA NERVIOSO 1. La comunicación nerviosa El sistema nervioso es el encargado de recibir señales, transformarlas en impulsos y transmitirlas a través del cuerpo de los organismos. Esta formado por
EL SISTEMA NERVIOSO 1. La comunicación nerviosa El sistema nervioso es el encargado de recibir señales, transformarlas en impulsos y transmitirlas a través del cuerpo de los organismos. Esta formado por
Cintya Borroni G. MV. Msc
 S. NERVIOSO 2 Cintya Borroni G. MV. Msc [email protected] MÉDULA ESPINAL VÍAS NERVIOSAS Aferencias: Sensoriales Sensitivas Eferencias: Efecto VÍAS NERVIOSAS SN somático Aferente somático - AS Eferente
S. NERVIOSO 2 Cintya Borroni G. MV. Msc [email protected] MÉDULA ESPINAL VÍAS NERVIOSAS Aferencias: Sensoriales Sensitivas Eferencias: Efecto VÍAS NERVIOSAS SN somático Aferente somático - AS Eferente
Sistema nervioso (SN)
 Sistema nervioso (SN) Es el conjunto de órganos formados principalmente por tejido nervioso en asociación con otros tejidos encargado de recibir estímulos y elaborar las respuestas correspondientes. El
Sistema nervioso (SN) Es el conjunto de órganos formados principalmente por tejido nervioso en asociación con otros tejidos encargado de recibir estímulos y elaborar las respuestas correspondientes. El
SISTEMA NERVIOSO Y ENDOCRINO. martes, 19 de marzo de 13
 SISTEMA NERVIOSO Y ENDOCRINO El SISTEMA NERVIOSO se encarga de recibir la información y elaborar las respuestas adecuadas. E s e l procesador de información: coordina y relaciona todas las funciones corporales.
SISTEMA NERVIOSO Y ENDOCRINO El SISTEMA NERVIOSO se encarga de recibir la información y elaborar las respuestas adecuadas. E s e l procesador de información: coordina y relaciona todas las funciones corporales.
CONOCIMIENTO DEL MEDIO 6º. Sistema Nervioso
 CONOCIMIENTO DEL MEDIO 6º Sistema Nervioso Índice Qué es el sistema nervioso? página 3 Las Neuronas página 4 Sistema Nervioso Central página 7 Sistema Nervioso Periférico página 12 Sistema Nervioso Autónomo
CONOCIMIENTO DEL MEDIO 6º Sistema Nervioso Índice Qué es el sistema nervioso? página 3 Las Neuronas página 4 Sistema Nervioso Central página 7 Sistema Nervioso Periférico página 12 Sistema Nervioso Autónomo
Los tejidos animales
 Los tejidos animales Tejidos animales Los tipos básicos de tejidos son: epitelial, conectivo, muscular, nervioso. Tejidos epiteliales o epitelios Tejidos epiteliales Según su función se clasifican en:
Los tejidos animales Tejidos animales Los tipos básicos de tejidos son: epitelial, conectivo, muscular, nervioso. Tejidos epiteliales o epitelios Tejidos epiteliales Según su función se clasifican en:
CARRERA DE TÉCNICOS PARA BIOTERIO HISTOLOGÍA SISTEMA NERVIOSO
 CARRERA DE TÉCNICOS PARA BIOTERIO HISTOLOGÍA SISTEMA NERVIOSO Autores: Silvina Diaz (Ayudante de 1º) Adelaida Sánchez (Profesora Adjunta) Año 2006 Tejido y Sistema Nervioso 1. Generalidades El tejido nervioso
CARRERA DE TÉCNICOS PARA BIOTERIO HISTOLOGÍA SISTEMA NERVIOSO Autores: Silvina Diaz (Ayudante de 1º) Adelaida Sánchez (Profesora Adjunta) Año 2006 Tejido y Sistema Nervioso 1. Generalidades El tejido nervioso
Sistema Nervioso Somático: Realiza el control de las funciones voluntarias, las que permiten al organismo su relación con el medio externo.
 ORGANIZACIÓN FUNCIONAL DEL SISTEMA NERVIOSO El sistema nervioso es el encargado de llevar a cabo la mayoría de las funciones de control y coordinación de actividades en los organismos superiores. En su
ORGANIZACIÓN FUNCIONAL DEL SISTEMA NERVIOSO El sistema nervioso es el encargado de llevar a cabo la mayoría de las funciones de control y coordinación de actividades en los organismos superiores. En su
SISTEMA NERVIOSO SISTEMA NERVIOSO CENTRAL. Álvaro López ENCÉFALO: CEREBRO, CEREBELO, BULBO, SALIDA INSTRUCCIONES A MÚSCULOS O GLÁNDULAS
 ENTRADA RECEPTORES SENSORIALES SALIDA INSTRUCCIONES A MÚSCULOS O GLÁNDULAS PROCESAMIENTO Álvaro López MEMORIA prosencéfalo hipotálamo peces prosencéfalo roedores infundíbulo prosencéfalo humanos Pituitaria
ENTRADA RECEPTORES SENSORIALES SALIDA INSTRUCCIONES A MÚSCULOS O GLÁNDULAS PROCESAMIENTO Álvaro López MEMORIA prosencéfalo hipotálamo peces prosencéfalo roedores infundíbulo prosencéfalo humanos Pituitaria
FUNDAMENTOS DE PSICOBIOLOGIA
 FUNDAMENTOS DE PSICOBIOLOGIA Apuntes Tema 6 Bernardo R. Japón [email protected] FUNDAMENTOS DE PSICOBIOLOGIA Apuntes Tema 6 Bernardo R. Japón [email protected] TEMA 6: ORGANIZACIÓN GENERAL
FUNDAMENTOS DE PSICOBIOLOGIA Apuntes Tema 6 Bernardo R. Japón [email protected] FUNDAMENTOS DE PSICOBIOLOGIA Apuntes Tema 6 Bernardo R. Japón [email protected] TEMA 6: ORGANIZACIÓN GENERAL
TEMA 2. Bases biológicas de la conducta
 TEMA 2. Bases biológicas de la conducta 2.1.- La arquitectura del cerebro 2.2.- Las funciones mentales en el cerebro 2.3.- Métodos de estudio del cerebro 2.1.- La arquitectura del cerebro 2.1.1.- Mente
TEMA 2. Bases biológicas de la conducta 2.1.- La arquitectura del cerebro 2.2.- Las funciones mentales en el cerebro 2.3.- Métodos de estudio del cerebro 2.1.- La arquitectura del cerebro 2.1.1.- Mente
ANATOMÍA T 15. Sistema nervioso
 ANATOMÍA T 15. Sistema nervioso 1. Órganos y divisiones del sistema nervioso 2. Células del sistema nervioso Neuronas Glía 3. Nervios y vías nerviosas 4. Arcos reflejos 5. Impulsos nerviosos 6. Sinapsis
ANATOMÍA T 15. Sistema nervioso 1. Órganos y divisiones del sistema nervioso 2. Células del sistema nervioso Neuronas Glía 3. Nervios y vías nerviosas 4. Arcos reflejos 5. Impulsos nerviosos 6. Sinapsis
EMBRIOLOGÍA DEL SISTEMA NERVIOSO
 EMBRIOLOGÍA DEL SISTEMA NERVIOSO 1 EMBRIOLOGÍA DEL SISTEMA NERVIOSO Los procesos de inducción, migración y diferenciación celular que se llevan a cabo durante la formación del tejido nervioso generan un
EMBRIOLOGÍA DEL SISTEMA NERVIOSO 1 EMBRIOLOGÍA DEL SISTEMA NERVIOSO Los procesos de inducción, migración y diferenciación celular que se llevan a cabo durante la formación del tejido nervioso generan un
TEMA 1. FISIOLOGÍA DEL NERVIO.
 TEMA 1. FISIOLOGÍA DEL NERVIO. GENERALIDADES. LA NEURONA. LAS CÉLULAS DE NEUROGLÍA. MENINGES. LÍQUIDO CEFALORRAQUÍDEO. GENERALIDADES La Neurofisiología es la parte de la Fisiología que estudia las funciones
TEMA 1. FISIOLOGÍA DEL NERVIO. GENERALIDADES. LA NEURONA. LAS CÉLULAS DE NEUROGLÍA. MENINGES. LÍQUIDO CEFALORRAQUÍDEO. GENERALIDADES La Neurofisiología es la parte de la Fisiología que estudia las funciones
Consideraciones biológicas y sociales
 Consideraciones biológicas y sociales El aparato más complejo de la naturaleza es el sistema nervioso, en particular el cerebro, es la estructura responsable de que el hombre aprenda, memorice, razone,
Consideraciones biológicas y sociales El aparato más complejo de la naturaleza es el sistema nervioso, en particular el cerebro, es la estructura responsable de que el hombre aprenda, memorice, razone,
1. LOS SERES VIVOS RESPONDEN A LOS ESTIMULOS DEL MEDIO:
 Guia de Contenidos Biología TERCEROS MEDIOS Tema: Sistema Nervioso Objetivos 1: - Identificar la organización general del sistema nervioso. - Conocer la anatomía de la neurona. - Determinar las propiedades
Guia de Contenidos Biología TERCEROS MEDIOS Tema: Sistema Nervioso Objetivos 1: - Identificar la organización general del sistema nervioso. - Conocer la anatomía de la neurona. - Determinar las propiedades
Sistema de Coordinación II. Sistema Nervioso-Sistema Endocrino
 Sistema de Coordinación II Sistema Nervioso-Sistema Endocrino SISTEMA NERVIOSO PERIFERICO Está formado por nervios que conducen los impulsos nerviosos relacionados con el sistema cerebro-espinal con los
Sistema de Coordinación II Sistema Nervioso-Sistema Endocrino SISTEMA NERVIOSO PERIFERICO Está formado por nervios que conducen los impulsos nerviosos relacionados con el sistema cerebro-espinal con los
Funcionalmente las neuronas se pueden clasificar en tres tipos: Neuronas sensitivas: aisladas o localizadas en órganos sensoriales o en zonas del
 LA NEURONA La neurona es considerada la unidad estructural y funcional fundamental del sistema nervioso. Esto quiere decir que las diferentes estructuras del sistema nervioso tienen como base grupos de
LA NEURONA La neurona es considerada la unidad estructural y funcional fundamental del sistema nervioso. Esto quiere decir que las diferentes estructuras del sistema nervioso tienen como base grupos de
SISTEMA NERVIOSO CENTRAL
 SISTEMA NERVIOSO CENTRAL 1. INTRODUCCIÓN El sistema nervioso junto con el sistema endocrino es quien desempeña la mayoría de las funciones del organismo cuyo propósito principal es mantener el equilibrio
SISTEMA NERVIOSO CENTRAL 1. INTRODUCCIÓN El sistema nervioso junto con el sistema endocrino es quien desempeña la mayoría de las funciones del organismo cuyo propósito principal es mantener el equilibrio
Sistema nervioso Sistema Nervioso
 Sistema nervioso 1. Función general del sistema nervioso El Sistema, el más complejo y desconocido de todos los que conforman el cuerpo humano, asegura junto con el Sistema Endocrino, las funciones de
Sistema nervioso 1. Función general del sistema nervioso El Sistema, el más complejo y desconocido de todos los que conforman el cuerpo humano, asegura junto con el Sistema Endocrino, las funciones de
NEUROHIPÓFISIS. EPÍFISIS
 49 NEUROHIPÓFISIS. EPÍFISIS ESTRUCTURA DEL TEMA: 49.1. Hipófisis posterior o neurohipófisis: - Lóbulo posterior. 49.2. Epífisis. 49.1. HIPÓFISIS POSTERIOR O NEUROHIPÓFISIS La hipófisis posterior o neurohipófisis
49 NEUROHIPÓFISIS. EPÍFISIS ESTRUCTURA DEL TEMA: 49.1. Hipófisis posterior o neurohipófisis: - Lóbulo posterior. 49.2. Epífisis. 49.1. HIPÓFISIS POSTERIOR O NEUROHIPÓFISIS La hipófisis posterior o neurohipófisis
EL SISTEMA NERVIOSO. Fig. 1 El Sistema Nervioso
 EL SISTEMA NERVIOSO Ante todo, debemos dejar establecido que las divisiones artificiales en tejidos, órganos, aparatos, sistemas, etc., resultan útiles con motivos de facilitar la comprensión, pero recordemos
EL SISTEMA NERVIOSO Ante todo, debemos dejar establecido que las divisiones artificiales en tejidos, órganos, aparatos, sistemas, etc., resultan útiles con motivos de facilitar la comprensión, pero recordemos
TEMA 1: CELULAS DEL SISTEMA NERVIOSO
 TEMA 1: CELULAS DEL SISTEMA NERVIOSO Dos son los tipos fundamentales de células cerebrales: Las neuronas, principales portadoras de información y las células de la glía, con misión auxiliar. Página 2 Cuántas
TEMA 1: CELULAS DEL SISTEMA NERVIOSO Dos son los tipos fundamentales de células cerebrales: Las neuronas, principales portadoras de información y las células de la glía, con misión auxiliar. Página 2 Cuántas
La relación con el medio
 Ciencias de la Naturaleza 2.º ESO Unidad 2 Ficha 1 La relación con el medio Un estímulo es un cambio que se produce en el medio externo o interno y que provoca una respuesta en el organismo. 1. Lee el
Ciencias de la Naturaleza 2.º ESO Unidad 2 Ficha 1 La relación con el medio Un estímulo es un cambio que se produce en el medio externo o interno y que provoca una respuesta en el organismo. 1. Lee el
Embriología del Sistema Nervioso
 Depto. de Anatomía, Escuela de Medicina Pontificia Universidad Católica de Chile Curso de Neuroanatomía. [email protected]. Embriología del Sistema Nervioso Introducción Los procesos de inducción, migración
Depto. de Anatomía, Escuela de Medicina Pontificia Universidad Católica de Chile Curso de Neuroanatomía. [email protected]. Embriología del Sistema Nervioso Introducción Los procesos de inducción, migración
SISTEMA NERVIOSO. Dra. Mercedes Castro Neuropediatra.
 SISTEMA NERVIOSO Dra. Mercedes Castro Neuropediatra. Propiedades Generales del Sistema Nervioso El sistema nervioso está formado por el tejido nervioso. Su principal función es la comunicación entre las
SISTEMA NERVIOSO Dra. Mercedes Castro Neuropediatra. Propiedades Generales del Sistema Nervioso El sistema nervioso está formado por el tejido nervioso. Su principal función es la comunicación entre las
Introducción y organización del sistema nervioso. Neurobiología de la neurona y de la neuroglia
 ÍNDICE Prefacio................................................. iii Agradecimientos............................................. iv Atlas en color del cerebro..................................... xi CAPÍTULO
ÍNDICE Prefacio................................................. iii Agradecimientos............................................. iv Atlas en color del cerebro..................................... xi CAPÍTULO
ORGANIZACIÓN ANATOMICA Y FUNCIONAL DEL SISTEMA NERVIOSO. Fundamentos de Neurociencias Facultad de Psicología Área de la Salud
 ORGANIZACIÓN ANATOMICA Y FUNCIONAL DEL SISTEMA NERVIOSO Fundamentos de Neurociencias Facultad de Psicología Área de la Salud UNIDAD ELEMENTAL DEL SISTEMA NERVIOSO Neuronas y neuroglia EL TEJIDO NERVIOSO
ORGANIZACIÓN ANATOMICA Y FUNCIONAL DEL SISTEMA NERVIOSO Fundamentos de Neurociencias Facultad de Psicología Área de la Salud UNIDAD ELEMENTAL DEL SISTEMA NERVIOSO Neuronas y neuroglia EL TEJIDO NERVIOSO
Tejido Muscular. La célula o fibra muscular es la unidad estructural y funcional del tejido muscular
 Tejido Muscular La célula o fibra muscular es la unidad estructural y funcional del tejido muscular Cuando decimos fibra muscular no nos estamos refiriendo a un tipo de fibra extracelular, como es el caso
Tejido Muscular La célula o fibra muscular es la unidad estructural y funcional del tejido muscular Cuando decimos fibra muscular no nos estamos refiriendo a un tipo de fibra extracelular, como es el caso
TEMA 6. RELACIÓN Y COORDINACIÓN HUMANAS I
 TEMA 6. RELACIÓN Y COORDINACIÓN HUMANAS I LOS SISTEMAS DE RELACIÓN Y COORDINACIÓN La función de relación consiste en la capacidad de un ser vivo para captar estímulos del medio y elaborar respuestas adecuadas
TEMA 6. RELACIÓN Y COORDINACIÓN HUMANAS I LOS SISTEMAS DE RELACIÓN Y COORDINACIÓN La función de relación consiste en la capacidad de un ser vivo para captar estímulos del medio y elaborar respuestas adecuadas
Sistema nervioso central.
 Universidad Santo Tomás. Escuela de Medicina Veterinaria. Anatomía I. Sistema nervioso central. Dr. César Caro Munizaga, DVM. Sistema nervioso. Divisiones anatómica y funcional. Sistema nervioso autónomo
Universidad Santo Tomás. Escuela de Medicina Veterinaria. Anatomía I. Sistema nervioso central. Dr. César Caro Munizaga, DVM. Sistema nervioso. Divisiones anatómica y funcional. Sistema nervioso autónomo
Organización del Sistema Nervioso
 Organización del Sistema Nervioso Héctor L. Santiago, Ph.D. INPE 6998 REGULACION NEUROQUIMICA Organización del Sistema Nervioso Sistema Nervioso Central (CNS) Cerebro Médula Espinal Sistema Nervioso Periferal
Organización del Sistema Nervioso Héctor L. Santiago, Ph.D. INPE 6998 REGULACION NEUROQUIMICA Organización del Sistema Nervioso Sistema Nervioso Central (CNS) Cerebro Médula Espinal Sistema Nervioso Periferal
HISTOLOGÍA ANIMAL BIOLOGÍA 1º DE BACHILLERATO
 HISTOLOGÍA ANIMAL BIOLOGÍA 1º DE BACHILLERATO TEJIDO EPITELIAL Sólo está constituido por células que están muy próximas unas a otras. Entre las células existen mecanismos de unión que son especializaciones
HISTOLOGÍA ANIMAL BIOLOGÍA 1º DE BACHILLERATO TEJIDO EPITELIAL Sólo está constituido por células que están muy próximas unas a otras. Entre las células existen mecanismos de unión que son especializaciones
Concepto de Fisiología. Ciencia que estudia las funciones vitales de un organismo sano.
 Concepto de Fisiología. Fisiología: Ciencia que estudia las funciones vitales de un organismo sano. 1. Procesos concernientes al funcionamiento coordinado de los diferentes sistemas. 2.Procesos relacionados
Concepto de Fisiología. Fisiología: Ciencia que estudia las funciones vitales de un organismo sano. 1. Procesos concernientes al funcionamiento coordinado de los diferentes sistemas. 2.Procesos relacionados
PASO 1 NERVIOSO: Médula espinal, tronco encefálico y LCE
 PASO 1 NERVIOSO: Médula espinal, tronco encefálico y LCE Generalidades Por razones didácticas, el sistema nervioso se divide para su estudio en dos principales componentes: uno el Sistema Nervioso Central
PASO 1 NERVIOSO: Médula espinal, tronco encefálico y LCE Generalidades Por razones didácticas, el sistema nervioso se divide para su estudio en dos principales componentes: uno el Sistema Nervioso Central
Es un sistema que poseen todos los animales, cuyas funciones son básicamente tres: Sensitiva. Integradora. Motora. Irritabilidad.
 El sistema nervioso Sistema nervioso Es un sistema que poseen todos los animales, cuyas funciones son básicamente tres: Sensitiva. Integradora. Motora. Irritabilidad. Como está organizado el sistema nervioso
El sistema nervioso Sistema nervioso Es un sistema que poseen todos los animales, cuyas funciones son básicamente tres: Sensitiva. Integradora. Motora. Irritabilidad. Como está organizado el sistema nervioso
FUNCIONES DEL SISTEMA NERVIOSO: CONTROL ESPINAL DEL MOVIMIENTO
 FUNCIONES DEL SISTEMA NERVIOSO: CONTROL ESPINAL DEL MOVIMIENTO FUNCIONES DEL SISTEMA NERVIOSO SISTEMA SENSORIAL : Capta la información. SISTEMA INTEGRADOR : Analiza los estímulos recibidos y decide las
FUNCIONES DEL SISTEMA NERVIOSO: CONTROL ESPINAL DEL MOVIMIENTO FUNCIONES DEL SISTEMA NERVIOSO SISTEMA SENSORIAL : Capta la información. SISTEMA INTEGRADOR : Analiza los estímulos recibidos y decide las
b) Se pueden realizar cortes de especímenes congelados con un criostato. a) Ramón y Cajal hizo observó las neuronas al microscopio electrónico.
 1.- Señale la respuesta correcta: a) La fijación se puede hacer con formol. Se pueden realizar cortes de especímenes congelados con un criostato. La fijación se puede hacer con formol y glutaraldehído.
1.- Señale la respuesta correcta: a) La fijación se puede hacer con formol. Se pueden realizar cortes de especímenes congelados con un criostato. La fijación se puede hacer con formol y glutaraldehído.
El profesor orientará las tareas a realizar en la actividad y el resto de las mismas serán realizadas en estudio independiente.
 Tema: Sistema Nervioso y Receptores de la Sensibilidad Especial. Asunto: Sistema Nervioso Central: Cerebelo y Médula Espinal. Sistema Nervioso Periférico: Nervio periférico y Ganglios nerviosos. Receptores
Tema: Sistema Nervioso y Receptores de la Sensibilidad Especial. Asunto: Sistema Nervioso Central: Cerebelo y Médula Espinal. Sistema Nervioso Periférico: Nervio periférico y Ganglios nerviosos. Receptores
(1º Bach.) SIGNIFICADO EVOLUTIVO DEL SISTEMA NERVIOSO DIFERENCIAS ENTRE SISTEMA NERVIOSO CENTRAL Y PERIFÉRICO
 Tema 5: Sistemas de coordinación. (3º ESO) CRITERIOS DE EVALUACIÓN 1. Identificar los dos sistemas involucrados en la coordinación y relación en el cuerpo humano, y explicar la función que realizan. (Objetivo
Tema 5: Sistemas de coordinación. (3º ESO) CRITERIOS DE EVALUACIÓN 1. Identificar los dos sistemas involucrados en la coordinación y relación en el cuerpo humano, y explicar la función que realizan. (Objetivo
Biología y geología. Tramo III
 Unidad 1: La organización del cuerpo humano Introducción: El ser humano, como ser vivo que es, está constituido por un cuerpo en el que podemos distinguir varios niveles de organización estructural y funcional.
Unidad 1: La organización del cuerpo humano Introducción: El ser humano, como ser vivo que es, está constituido por un cuerpo en el que podemos distinguir varios niveles de organización estructural y funcional.
NEUROHISTOLOGÍA. - Funcional: al ser en la neurona donde se recibe la información y se elabora una respuesta frente al estímulo.
 NEUROHISTOLOGÍA Clase Dr. Matamala Estructura histológica del Sistema Nervioso. El sistema nervioso presenta neuronas y células gliales que tienen origen ectodérmico junto a vasos sanguíneos y meninges
NEUROHISTOLOGÍA Clase Dr. Matamala Estructura histológica del Sistema Nervioso. El sistema nervioso presenta neuronas y células gliales que tienen origen ectodérmico junto a vasos sanguíneos y meninges
PREGUNTAS DE SELECCIÓN MULTIPLE CON UNICA RESPUESTA
 PREGUNTAS DE SELECCIÓN MULTIPLE CON MULTIPLE RESPUESTA SELECCIONA LA RESPUESTA CORRECTA DE ACUERDO CON LAS SIGUIENTES INDICACIONES MARQUE A SI 1 Y 2 SON CORRECTAS MARQUE B SI 2 Y 3 SON CORRECTAS MARQUE
PREGUNTAS DE SELECCIÓN MULTIPLE CON MULTIPLE RESPUESTA SELECCIONA LA RESPUESTA CORRECTA DE ACUERDO CON LAS SIGUIENTES INDICACIONES MARQUE A SI 1 Y 2 SON CORRECTAS MARQUE B SI 2 Y 3 SON CORRECTAS MARQUE
TEMA 17-SISTEMAS NERVIOSO Y HORMONAL
 TEMA 17-SISTEMAS NERVIOSO Y HORMONAL FUNCIÓN DE RELACIÓN 1-LOS SISTEMAS DE COORDINACIÓN La función de relación consiste en la capacidad de un ser vivo para captar estímulos del medio y elaborar respuestas
TEMA 17-SISTEMAS NERVIOSO Y HORMONAL FUNCIÓN DE RELACIÓN 1-LOS SISTEMAS DE COORDINACIÓN La función de relación consiste en la capacidad de un ser vivo para captar estímulos del medio y elaborar respuestas
Funciones del sistema nervioso
 Funciones del sistema nervioso transducción de señales : 1. recepción de señales externas e internas, vía órganos de los sentidos y nocireceptores 2. integración- de la información (SNC-cerebro y médula
Funciones del sistema nervioso transducción de señales : 1. recepción de señales externas e internas, vía órganos de los sentidos y nocireceptores 2. integración- de la información (SNC-cerebro y médula
Compartimentos cerebrales
 Compartimentos cerebrales 1 Metabolismo cerebral El encéfalo requiere oxígeno y nutrientes para cubrir necesidades metabólicas. En reposo el metabolismo cerebral es 7.5 veces el met. promedio del resto
Compartimentos cerebrales 1 Metabolismo cerebral El encéfalo requiere oxígeno y nutrientes para cubrir necesidades metabólicas. En reposo el metabolismo cerebral es 7.5 veces el met. promedio del resto
SISTEMA NERVIOSO Y ENDOCRINO FUNCIÓN DE RELACIÓN I
 SISTEMA NERVIOSO Y ENDOCRINO FUNCIÓN DE RELACIÓN I Profesora: Milagros López García 3º ESO Biología y Geología Recuerda La función de relación consiste en la capacidad de un ser vivo para captar estímulos
SISTEMA NERVIOSO Y ENDOCRINO FUNCIÓN DE RELACIÓN I Profesora: Milagros López García 3º ESO Biología y Geología Recuerda La función de relación consiste en la capacidad de un ser vivo para captar estímulos
FISIOLOGÍA DEL CUERPO HUMANO
 FISIOLOGÍA DEL CUERPO HUMANO FUNCIONES VITALES NUTRICIÓN RELACIÓN REPRODUCCIÓN LA FUNCIÓN DE RELACIÓN La función de relación permite a los seres vivos captar los cambios (estímulos) que se producen fuera
FISIOLOGÍA DEL CUERPO HUMANO FUNCIONES VITALES NUTRICIÓN RELACIÓN REPRODUCCIÓN LA FUNCIÓN DE RELACIÓN La función de relación permite a los seres vivos captar los cambios (estímulos) que se producen fuera
3. La organización pluricelular
 TEJIDOS VEGETALES Tejidos vegetales: tejidos meristemáticos Son los responsables del crecimiento del vegetal. Son pequeñas, tienen forma poliédrica, con paredes finas y vacuolas pequeñas y abundantes.
TEJIDOS VEGETALES Tejidos vegetales: tejidos meristemáticos Son los responsables del crecimiento del vegetal. Son pequeñas, tienen forma poliédrica, con paredes finas y vacuolas pequeñas y abundantes.
En un organismo unicelular, como una bacteria o un protista, la célula única debe realizar todas las funciones necesarias para la vida.
 HISTOLOGIA ANIMAL En un organismo unicelular, como una bacteria o un protista, la célula única debe realizar todas las funciones necesarias para la vida. Tejidos Los animales pueden alcanzar grandes tallas
HISTOLOGIA ANIMAL En un organismo unicelular, como una bacteria o un protista, la célula única debe realizar todas las funciones necesarias para la vida. Tejidos Los animales pueden alcanzar grandes tallas
RESUMEN DEL SISTEMA NERVIOSO Dra. C. Lorenzo
 RESUMEN DEL SISTEMA NERVIOSO Dra. C. Lorenzo 1. El sistema nervioso controla e integra todas las acciones del cuerpo, percibiendo los cambios, interpretándolos y reaccionando a ellos. 2. El sistema nervioso
RESUMEN DEL SISTEMA NERVIOSO Dra. C. Lorenzo 1. El sistema nervioso controla e integra todas las acciones del cuerpo, percibiendo los cambios, interpretándolos y reaccionando a ellos. 2. El sistema nervioso
Biología y Geología 3º ESO
 TEMA 6: SISTEMAS NERVIOSO Y ENDOCRINO 1/ La función de relación y el sistema nervioso humano (páginas 88 y 89) Biología y Geología 3º ESO De este punto tienes que saber: -En qué consiste la función de
TEMA 6: SISTEMAS NERVIOSO Y ENDOCRINO 1/ La función de relación y el sistema nervioso humano (páginas 88 y 89) Biología y Geología 3º ESO De este punto tienes que saber: -En qué consiste la función de
CITOLOGÍA E HISTOLOGÍA VETERINARIA
Tema 16. Fibra nerviosa: concepto, morfología y tipos de fibras. Relaciones interneuronales. Sinapsis: concepto, morfología y tipos. Terminaciones nerviosas periféricas: concepto y tipos. Terminaciones
Tema 16. Fibra nerviosa: concepto, morfología y tipos de fibras. Relaciones interneuronales. Sinapsis: concepto, morfología y tipos. Terminaciones nerviosas periféricas: concepto y tipos. Terminaciones
Las neuronas se distinguen por su aspecto morfológico, presentan un soma o cuerpo y prolongaciones citoplasmáticas que se denominan axón y dendrita
 TEJIDO NERVIOSO. MSc. Belén Z. Iglesias Ramírez Dr. Andrés Dovale Borjas El tejido nervioso, al igual que los demás tejidos básicos, está compuesto por células, sustancia intercelular y líquido tisular.
TEJIDO NERVIOSO. MSc. Belén Z. Iglesias Ramírez Dr. Andrés Dovale Borjas El tejido nervioso, al igual que los demás tejidos básicos, está compuesto por células, sustancia intercelular y líquido tisular.
HISTOLOGÍA. Rama de las ciencias que se ocupa del estudio de los tejidos.
 HISTOLOGÍA Rama de las ciencias que se ocupa del estudio de los tejidos. Tejido: agregado o conjunto de células que tienen igual función e igual origen embriológico. Composición de los tejidos a) Células:
HISTOLOGÍA Rama de las ciencias que se ocupa del estudio de los tejidos. Tejido: agregado o conjunto de células que tienen igual función e igual origen embriológico. Composición de los tejidos a) Células:
2. CELULAS DEL SISTEMA NERVIOSO CENTRAL
 3 2. CELULAS DEL SISTEMA NERVIOSO CENTRAL La célula nerviosa y sus prolongaciones reciben el nombre de neurona y tiene como característica el ser excitables y especializarse en la recepción y conducción
3 2. CELULAS DEL SISTEMA NERVIOSO CENTRAL La célula nerviosa y sus prolongaciones reciben el nombre de neurona y tiene como característica el ser excitables y especializarse en la recepción y conducción
INTRODUCCIÓN A LOS SISTEMAS Y TEGUMENTOS. Dr. Julio Cárdenas V. Fac. Cs. Químicas y Farmacéuticas
 INTRODUCCIÓN A LOS SISTEMAS Y TEGUMENTOS Dr. Julio Cárdenas V. Fac. Cs. Químicas y Farmacéuticas Organización General Cuerpo Humano Células Tejidos Órganos Sistemas CUERPO HUMANO Rango de visibilidad Tipos
INTRODUCCIÓN A LOS SISTEMAS Y TEGUMENTOS Dr. Julio Cárdenas V. Fac. Cs. Químicas y Farmacéuticas Organización General Cuerpo Humano Células Tejidos Órganos Sistemas CUERPO HUMANO Rango de visibilidad Tipos
Las neuronas se clasifican en : sensoriales, motoras o interneuronas. Las neuronas sensoriales o neuronas aferentes, son receptores (olfatorios,
 EL SISTEMA NERVIOSO Para que un conjunto tan complicado como el cuerpo humano funcione adecuadamente, se requiere un sistema coordinador de proporcionada complejidad: el sistema nervioso compuesto de ;
EL SISTEMA NERVIOSO Para que un conjunto tan complicado como el cuerpo humano funcione adecuadamente, se requiere un sistema coordinador de proporcionada complejidad: el sistema nervioso compuesto de ;
GUÍA PRÁCTICA Nº 22 NEURO III VÍAS DE CONDUCCIÓN Y SENTIDOS
 CÁTEDRA DE ANATOMÍA HUMANA LICENCIATURA EN OBSTETRICIA FACULTAD DE CIENCIAS MÉDICAS UNIVERSIDAD DE BUENOS AIRES GUÍA PRÁCTICA Nº 22 NEURO III VÍAS DE CONDUCCIÓN Y SENTIDOS Docentes de anatomía en obstetricia
CÁTEDRA DE ANATOMÍA HUMANA LICENCIATURA EN OBSTETRICIA FACULTAD DE CIENCIAS MÉDICAS UNIVERSIDAD DE BUENOS AIRES GUÍA PRÁCTICA Nº 22 NEURO III VÍAS DE CONDUCCIÓN Y SENTIDOS Docentes de anatomía en obstetricia
SISTEMA NERVIOSO HUMANO
 SISTEMA NERVIOSO HUMANO El Sistema Nervioso es el gobernante y el coordinador de todas las funciones conscientes e inconscientes del cuerpo. - memoria - inteligencia - emociones - pensamiento - movimiento
SISTEMA NERVIOSO HUMANO El Sistema Nervioso es el gobernante y el coordinador de todas las funciones conscientes e inconscientes del cuerpo. - memoria - inteligencia - emociones - pensamiento - movimiento
GENERALIDADES DEL SISTEMA NERVIOSO INTRODUCCION CONCEPTOS BÁSICOS
 GENERALIDADES DEL SISTEMA NERVIOSO INTRODUCCION CONCEPTOS BÁSICOS Cuando un organismo es sometido a un cambio ambiental (S o estimulo), al cual es capaz de reaccionar, produce una respuesta apropiada.
GENERALIDADES DEL SISTEMA NERVIOSO INTRODUCCION CONCEPTOS BÁSICOS Cuando un organismo es sometido a un cambio ambiental (S o estimulo), al cual es capaz de reaccionar, produce una respuesta apropiada.
PSICOBIOLOGÍA URSO PIR-COPPA2013 OF. SONIA GONZÁLEZ QUEMAS DE CONTENIDOS
 PSICOBIOLOGÍA URSO PIR-COPPA2013 OF. SONIA GONZÁLEZ QUEMAS DE CONTENIDOS EMA 6. LA NEURONA Y LA GLÍA Neurona Dos regiones fundamentales: soma y neuritas (dendrita y axón) Estructura interna: Membrana Núcleo:
PSICOBIOLOGÍA URSO PIR-COPPA2013 OF. SONIA GONZÁLEZ QUEMAS DE CONTENIDOS EMA 6. LA NEURONA Y LA GLÍA Neurona Dos regiones fundamentales: soma y neuritas (dendrita y axón) Estructura interna: Membrana Núcleo:
Depto. de Anatomía, Escuela de Medicina Pontificia Universidad Católica de Chile Curso en línea de Neuroanatomía.
 Depto. de Anatomía, Escuela de Medicina Pontificia Universidad Católica de Chile Curso en línea de Neuroanatomía. [email protected]. Introducción El sistema nervioso central (SNC) es uno de los sistemas
Depto. de Anatomía, Escuela de Medicina Pontificia Universidad Católica de Chile Curso en línea de Neuroanatomía. [email protected]. Introducción El sistema nervioso central (SNC) es uno de los sistemas
Neuroanatomía General:
 Neuroanatomía General: El sistema nervioso humano, es sin lugar a duda, el dispositivo más complejo ideado por la naturaleza. No solo controla todos los procesos que ocurren en nuestro cuerpo recibiendo
Neuroanatomía General: El sistema nervioso humano, es sin lugar a duda, el dispositivo más complejo ideado por la naturaleza. No solo controla todos los procesos que ocurren en nuestro cuerpo recibiendo
Sistema Nervioso Central Recuerdo Anatómico
 Sistema Nervioso Central Recuerdo Anatómico M. Elisa de Castro Peraza Nieves Lorenzo Rocha Rosa Llabrés Solé Ana M. Perdomo Hernández M. Inmaculada Sosa Álvarez Organización Sistema Nervioso El Sistema
Sistema Nervioso Central Recuerdo Anatómico M. Elisa de Castro Peraza Nieves Lorenzo Rocha Rosa Llabrés Solé Ana M. Perdomo Hernández M. Inmaculada Sosa Álvarez Organización Sistema Nervioso El Sistema
Guía de actividades. efectores - información - músculos - Nervioso Central - percibimos - procesada - respuesta - receptores sensitivos
 1 I. Completa: Completa el texto con las siguientes palabras Guía de actividades Liceo N 1 Javiera Carrera Departamento de Biología Nivel: 3 medio Profesora Cinthia Lepe D. efectores - información - músculos
1 I. Completa: Completa el texto con las siguientes palabras Guía de actividades Liceo N 1 Javiera Carrera Departamento de Biología Nivel: 3 medio Profesora Cinthia Lepe D. efectores - información - músculos
